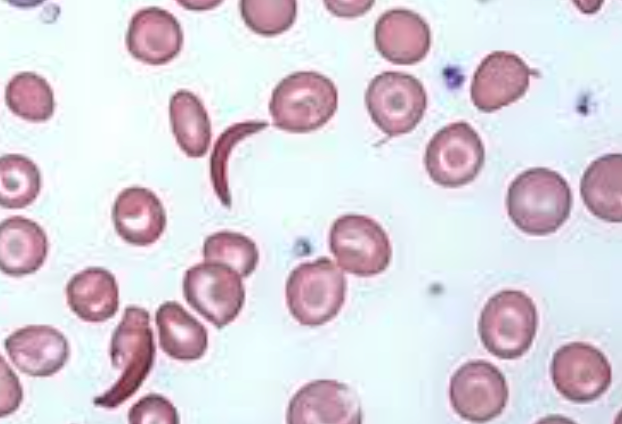

PEDIGREE
When constructing a pedigree, ask about miscarriages, stillbirths, and consanguinity. Take details from both sides of the family and record dates of birth rather than current ages.


- No skipping is dominant
- Skipping is autosomal recessive
- Autosomal male and female affected
- X-linked recessive, male only affected
- X-linked dominant, females are affected
| Inheritance Type | Key Characteristics | Chance of Inheritance | Affected Individuals | Examples of Disorders | Notes |
|---|---|---|---|---|---|
| Autosomal Dominant (AD) | - Affected individual carries the abnormal gene on one of a pair of autosomes. - Trait appears in every generation. - Males and females are equally affected. - Male-to-male transmission occurs. | - Each child of an affected parent has a 50% chance of inheriting the mutated gene. - Variation in expression, non-penetrance, new mutation, parental mosaicism, or homozygosity may occur. | - Affected individuals can have an affected parent or a new mutation. - Both sexes equally affected. | - Achondroplasia - Ehlers–Danlos syndrome - Familial hypercholesterolaemia - Marfan syndrome - Neurofibromatosis - Noonan syndrome - Osteogenesis imperfecta | - Traits generally involve mutations in genes coding for regulatory or structural proteins (e.g., collagen). |
| Autosomal Recessive (AR) | - Affected individuals are usually homozygous for the abnormal gene. - Each unaffected parent is a heterozygous carrier. - Risk varies between populations and is increased by consanguinity. | - If both parents are carriers, each child has a 25% chance of being affected. | - Affected children are usually born to unaffected parents who are carriers. | - Sickle cell disease - Thalassemia - Congenital adrenal hyperplasia - Cystic fibrosis - Friedreich ataxia - Galactosemia - Glycogen storage diseases - Hurler syndrome - Oculocutaneous albinism - Phenylketonuria | - Often affect metabolic pathways. |
| X-Linked Recessive | - Males are primarily affected. - Female carriers are usually healthy; occasionally show features of the disease. - Family history may be negative due to new mutations or gonadal mosaicism. | - Each son of a female carrier has a 50% risk of being affected. - Each daughter has a 50% risk of being a carrier. | - Daughters of affected males will all be carriers. - Sons of affected males will not be affected. | - Hemophilia A and B - Glucose-6-phosphate dehydrogenase deficiency - Color blindness - Duchenne muscular dystrophy - Fragile X syndrome | - Identifying female carriers is important for genetic counseling. |
| X-Linked Dominant | - Both males and females are affected. - Females carrying the mutation are affected; males have a more severe condition. | - Not specified, but typically involves affected females passing the mutation to offspring. | - Males with the mutation may have lethal conditions. - Females may have milder symptoms. | - Hypophosphataemic (vitamin D-resistant) rickets - Rett syndrome (in females) | - Unusual inheritance pattern compared to other types. |
Karyotyping
13 14 15 18 21 are compatible to life are incompatible to life
Down syndrome (trisomy 21)
 single palmar scar, kleniodactyl, sandal sign, flat occipital, hypothyroidism, constipitation, fatigue, liablity for leukemia
single palmar scar, kleniodactyl, sandal sign, flat occipital, hypothyroidism, constipitation, fatigue, liablity for leukemia
-
Meiotic Nondisjunction (94%):
-
Translocation (5%): translocation from 21 combination with 14 - may appear normal, with all chromosome intact, but abnormality in length, or combined with 21 it self.
-
Mosaicism (1%): In mosaicism, some of the cells are normal and some have trisomy 21.
Trisomy 18 (Edward Syndrome)
 over riding fingers, rocker bottom feet
over riding fingers, rocker bottom feet
Trisomy 13 (Patau Syndrome)
 Midline defect, eyes space, cleft.
Midline defect, eyes space, cleft.
Turner Syndrome (45X0)

 webbed neck, edema foot at birth, everything widening.
webbed neck, edema foot at birth, everything widening.
Klinefelter Syndrome (47, XXY)
 Large jaw, ear, truamas (iq)
Large jaw, ear, truamas (iq)
William Syndrome (d 7q11.23)

Achondroplasia (Autosomal dominant)
Mutation in the gene for fibroblast growth factor receptor 3 (FGFR3) on chromosome 4

Table
| Syndrome | Craniofacial/Physical Features | Medical Problems | Inheritance/Genetics | Other Anomalies | Treatment/Management | complications??? |
|---|---|---|---|---|---|---|
| Down Syndrome | Round face, flat nasal bridge, upslanted palpebral fissures, epicanthic folds, small mouth, ears | Delayed motor milestones, learning difficulties, short stature, infections, hearing/visual impairments | Meiotic nondisjunction (94%), translocation (5%), mosaicism (1%) | Short neck, single palmar creases, congenital heart defects, duodenal atresia, Hirschsprung disease | Supportive therapies, early intervention programs | |
| Trisomy 18 (Edward Syndrome) | Microcephaly, high forehead, rocker bottom feet, clubfoot, overlapping fingers, hypoplastic nails | Apneic episodes, poor feeding, failure to thrive, intellectual disability, heart defects (VSD, ASD, PDA) | Risk of recurrence <1%, higher with increased maternal age | None specified | Supportive care, management of symptoms | |
| Trisomy 13 (Patau Syndrome) | Cleft lip/palate, polydactyly, microcephaly, microphthalmia, scalp defects | Cardiac defects (PDA, VSD), genital anomalies, neural tube defects | Risk of recurrence <1%, higher with increased maternal age | Omphalocele, hernias | Supportive care, management of symptoms | |
| Turner Syndrome (45X0) | Short stature, lymphedema, shield chest, webbed neck, low posterior hairline, rotated ears | Ovarian dysgenesis, cardiac defects (bicuspid aortic valve, coarctation of aorta), renal anomalies | Absence of one set of genes from the short arm of one X chromosome | Increased risk of hypothyroidism, celiac disease, inflammatory bowel disease, gonadoblastoma | Growth hormone, estrogen therapy | |
| Klinefelter Syndrome (47, XXY) | Tall stature, gynecomastia, small penis, infertility, delayed secondary sexual characteristics | Language impairment, academic difficulty, osteoporosis, hypogonadism | 47,XXY karyotype with variants | Increased risk of pulmonary disease, varicose veins, ADHD | Testosterone replacement therapy | |
| Marfan Syndrome | Pectus carinatum/excavatum, wrist sign, scoliosis, high arched palate | Cardiovascular complications (aortic dilatation/dissection), ectopia lentis, dural ectasia | Autosomal dominant | Joint hypermobility, mitral valve prolapse, spontaneous pneumothorax, striae atrophicae | Annual echocardiogram, management of cardiovascular complications | |
| William Syndrome (7q11.23) | Short stature, characteristic facies, periorbital fullness, prominent lower lip | Congenital heart disease (supravalvular aortic stenosis), learning difficulties, sensorineural hearing loss | Deletion at chromosome band 7q11.23 | Transient neonatal hypercalcemia, strabismus, cataract | Supportive care, management of symptoms | |
| Achondroplasia | Short stature, marked shortening of limbs, large head, frontal bossing, depression of nasal bridge | Hydrocephalus, marked lumbar lordosis | Mutation in FGFR3 gene on chromosome 4, autosomal dominant, 50% new mutations | None specified | Growth hormone, limb lengthening |
Child 10 months old, doesnt eat well; poor feeding; sepsis, high fever. he had slight convulsion associated with vomitting.
febrile convulsion is exclusion not diagnosis
most important question is feeding. if child feeds well more like no abnormality.
meningitis image*** C
gram stain takes 2 hours to check for organism
| Category | Gram Stain Result | Organism | Description |
|---|---|---|---|
| Cocci | Blue (Positive) | Streptococci, Group A | Gram-positive cocci in chains; causes strep throat, skin infections, etc. |
| Red (Negative) | Meningococci (Neisseria meningitidis) | Gram-negative diplococci; causes meningitis and other serious infections. | |
| Bacilli | Red (Negative) | Tuberculosis (Mycobacterium tuberculosis) | Requires acid-fast stain due to waxy cell wall; presents atypically. |
| Cocco-bacilli | Red (Negative) | Haemophilus influenzae | Small, pleomorphic gram-negative bacteria; causes respiratory and invasive diseases. |
Stool analysis giarda lambia - metrondiazole treatment
culture takes 3 days …
electron microscope human rotavirus (vaccine may result in intruccuception) - common cause diarrhea in children -
blood smaer Hypchromic, microcytic anemia
- Beta thallesemia minor
- Iron deficiency anemia

Megaloblastic anaemia hypersegmented wbc
- Folic acid deficiency
- B12 deficiency

Sickling positive in blood smear
Hb electrophoresis to confirm diagnosis of sickle cell anemia.

Spherocytosis differential round blood
- Gram - sepsis
- intravascular hemmorhage
- Hereditary Spherocytosis
- Autoimmune Hemolytic Anemia (AIHA)
- Hemolytic Disease of the Newborn
- Burns
- Clostridial Sepsis
- Microangiopathic Hemolytic Anemia
- Transfusion Reactions

Ulcer
- Burn
- Truama
- Infection
- Chronic hemolytic anemia, sicklers
Chronic hemolytic picture
due thallassemia
zygomatic, frontal, parietal bossing due overactivation of hemolysis
Hair on end apperance on x-ray


Target cell
thallasemia

Malaria banana chape gametocyte Malaria falciparum

basophilic stri,.??
Lead poisoning
lead line in end femur.

fragmented rbcs with no platelets
- Hemolytic uremic syndrome
- DIC

bone/Air conduction
- normally close together,
- if seperated = conductive deafness
- if together values are low - senroirnal deafness
- if both - mixed

Meningococcemia Z
Necrotic rash materials, rashes, pampers, pneum
- elective intubation
- Iv line antibiotics 3rd generation ecphalosporins
- Iv steroids may be given

Malnutrition and Malabsorption
Malnutrition, malabsorption, short stature. 6-year-old child presents with frequent diarrhea for the last 2 years and pallor.
What features are shown in the picture?
Mention 2 possible causes?
- 6 years, weight: 12 kg, height: 103 cm
- Features of Down
When expect child to raise arm?
- 9 months
Facial Nerve Palsy
 Man pressing on side of face eliciting
Man pressing on side of face eliciting
A 10-day-old infant suffered a moderate severe HIE from which he recovered. He showed spastic posture.
What is the abnormality?
- Right facial nerve palsy
 Vitamin D dependent type 2, type of rickets finding usually present.
Vitamin D dependent type 2, type of rickets finding usually present.
Drinking Cup
Drinking cup on his own more than one year.

Iron Deficiency
Iron deficiency, koilonychia.
Jaundice
Jaundice: Physiological vs pathological.
- Conjugated vs unconjugated
| Aspect | Physiological Jaundice | Pathological Jaundice |
|---|---|---|
| Timing | Appears 2-3 days after birth, resolves in 2 weeks | Can occur at any age, often within 24 hours of birth |
| Cause | Immature liver in newborns | Underlying conditions (e.g., hemolytic disease, liver dysfunction) |
| Type of Bilirubin | Unconjugated (indirect) | Can be conjugated (direct) or unconjugated (indirect) |
| Treatment | Often self-resolving, may require phototherapy | Requires medical intervention to treat underlying cause |
| Aspect | Unconjugated Bilirubin | Conjugated Bilirubin |
|---|---|---|
| Definition | Not yet processed by the liver, fat-soluble | Processed by the liver, water-soluble |
| Indication | Liver immaturity or excessive breakdown of red blood cells | Liver or bile duct problems |
| Excretion | Not easily excreted, can accumulate in tissues | Excreted in bile |
Febrile Seizure
febrile seizure.
Gastrointestinal Seizure
seizure gastrointestinal.
- Serum electrolytes…
Caput Succedaneum / cephalohematoma?
Caput succedaneum, man child on bed crying.

Acrocephaly
Acrocephaly,, ALPORT

TORCH Infections
TORCH microcephaly causes macro for familial obstruction achondroplasia.
Mumps Presentation
Abscess in mouth, moving his mouth sideways, child mumps presentation Z
Eating Age
????
Kawasaki Syndrome
Tongue strawberry, fingernail peeling.
- Kawasaki Syndrome
Cystic Hygroma

Heterochromia
Heterochromia Y
Cephalohematoma
Bilateral cephalohematoma with jaundiced eye.
 #Z
#Z
Premature Infant
Extremely premature, red all over.
Post-Term Infant
Post-term scaling flakes meconium on skin.
Resuscitation
What is the most appropriate first step in the resuscitation of this infant?
- Intubation and direct…
Teeth Development
Two incisors out in 1 year.